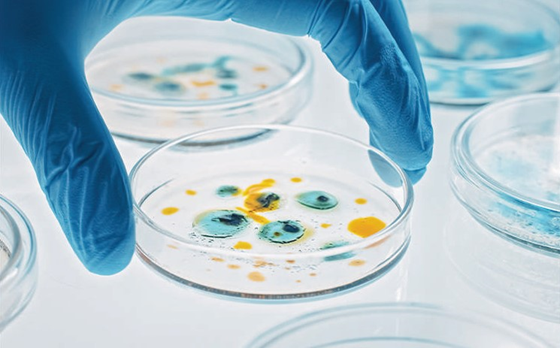
/images/65astargraduateacademyagalibraries/aga/aga_why_astar_main_image.tmb-rs560.webp?Culture=en&sfvrsn=220fc020_1

Why A*STAR
Science. It's at the heart of everything we do.
At the Agency for Science, Technology and Research (A*STAR), we are focused on pushing boundaries to develop Singapore’s scientific capabilities and ecosystem, as well as nurture the next generation of scientific leaders.
Home to a vibrant ecosystem, A*STAR’s boasts over 17 A*STAR research entities to drive cross-disciplinary and multi-sectoral research opportunities, facilitating diverse career pathways in science, engineering, academia, technopreneurship, and industry.
FY24 Key Achievements

Your Growth Comes First, Always.

At A*STAR, we invest in science and we invest in you— Because your growth comes first, always.
From the moment you join us as a scholar, you'll be supported through a comprehensive development framework designed to help you grow professionally, personally, and purposefully.
Many A*STAR scholars have gone on to lead impactful work in academia, industry, and public service. Through mentorship, leadership development, innovation training, and flexible career pathways, A*STAR prepares you for a career in Science and Technology.
Be part of a community to overcome challenges of tomorrow's science and research landscape.
At A*STAR, you will have the opportunity to work alongside world-class scientists in a dynamic research environment that fosters innovation and collaboration. With access to cutting-edge technology and state-of-the-art laboratories, you can contribute to groundbreaking research that drives real-world impact. The experience you gain here will equip you with industry-relevant skills and the ability to translate scientific discoveries into solutions that benefit Singapore and beyond.
A*STAR connects you with top research institutions, universities, and industry partners worldwide. Through international research collaborations, overseas attachments, and global partnerships, you will gain exposure to different scientific approaches and perspectives. Presenting your work at international conferences and engaging with experts across disciplines will help you expand your professional network and grow as a researcher.
Your journey at A*STAR is more than just research—it’s a structured pathway to success. You will receive mentorship from experienced researchers and scientific leaders who will help you refine your career goals and navigate different opportunities. The Vista Programme, a four-part series, provides scholars with strategic insights at key milestones during your A*STAR journey, preparing you to contribute meaningfully to Singapore’s public sector and become a future leader in R&D.
At A*STAR, you will be part of a community that is driving change through research. Whether in artificial intelligence, human health and potential, sustainability, or advanced manufacturing, A*STAR empowers you to work on projects that solve real-world challenges. Many A*STAR alumni have gone on to shape Singapore’s R&D landscape, excelling in academia, industry, and the public sector—and you can follow in their footsteps, making meaningful contributions to Singapore and beyond.
A*STAR ensures that you can focus on your research and studies by providing comprehensive financial support. Your scholarship will cover tuition fees, stipends, and research allowances, as well as funding for overseas exposure and conference participation. There are also special grants available for entrepreneurial and translational research projects, giving you the freedom to explore innovative solutions that can create real impact.
At A*STAR, you will be surrounded by a network of like-minded scholars and awardees who share your passion for science and discovery. You will become part of the A*STAR Scholar Network (ASN) and the A*STAR International Awardee Network (AIAN)—lifelong communities that provide opportunities to collaborate, exchange ideas, and support one another beyond the lab.
Finder Tool
Hear from our Scholars and Awardees /scholarships/home/scholars-stories
FAQs /scholarships/home/faqs
Do I need to have prior research experience?
While having prior research experience helps to boost your application, it is not mandatory. A*STAR will make a holistic assessment of each application and take into consideration other factors such your achievements in science/maths related competitions and CCAs.
What are the allowances like for the A*STAR scholarships?
During the PhD studies, A*STAR scholars receive competitive monthly allowance besides full sponsorship of the tuition fees. Please refer to the coverage section of the respective scholarship pages for further details.
My examination results are not available yet. Can I apply for the scholarship?
Yes, you may apply with your school preliminary results. Please send in your final results as soon as you receive it.
Do I need to secure a place at an overseas university before applying for the scholarship?
No, you may apply for the scholarship even if you have not secured admission to any overseas university yet
What qualities does A*STAR look for in a scholar?
In addition to academic excellence and a passion in science, we are looking for people who are committed to a research or research-related career in Singapore. A*STAR is making a significant investment in each scholar and the aim is for every scholar to be part of Singapore's Research, Innovation and Enterprise ecosystem.
Do I need to serve a bond?
For overseas scholarships students will have to serve a bond from 2-6 years.
















